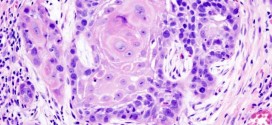

El linfoepitelioma anaplásico de schmincke. Durante los primeros años de vida de una persona, las células normales se dividen más rápidamente para permitir el crecimiento. El cuerpo está compuesto por billones de células vivas. Las células normales del cuerpo crecen, se dividen formando nuevas células y mueren de manera ordenada. Una vez que se llega a la edad adulta, la …
Leer MásEnfermedades
CARCINOMA VILIFORME DE LA CAVIDAD ORAL
El carcinoma viliforme de la cavidad oral. Durante los primeros años de vida de una persona, las células normales se dividen más rápidamente para permitir el crecimiento. El cuerpo está compuesto por billones de células vivas. Las células normales del cuerpo crecen, se dividen formando nuevas células y mueren de manera ordenada. Una vez que se llega a la edad …
Leer MásCOLANGIOCARCINOMA DE LA VESÍCULA BILIAR
El Colangiocarcinoma de la vesícula biliar. Tumor maligno en general de las vías biliares. El sistema para drenar la bilis, incluye los conductos o vías extrahepático, conductos biliares intra y la vesícula biliar. Son como una red de cañerías, llamados conductos que están conectados con la vesícula biliar, el intestino delgado y el hígado. El Colangiocarcinoma este tumor se ubica …
Leer MásHIPERPLASIA MALIGNA EPITELIAL ATÍPICA DE MAMA
La hiperplasia maligna epitelial atípica de mama. Durante los primeros años de vida de una persona, las células normales se dividen más rápidamente para permitir el crecimiento. El cuerpo está compuesto por billones de células vivas. Las células normales del cuerpo crecen, se dividen formando nuevas células y mueren de manera ordenada. Una vez que se llega a la edad …
Leer MásCARCINOMA METASTASICO DE LA AMIGDALA PALATINA
El carcinoma metastásico de la amígdala palatina. La amígdala palatina se desarrolla a partir de la segunda bolsa faríngea, entre el segundo y tercer arcos branquiales. En el tercer mes de la vida intrauterina, el epitelio de revestimiento bucofaríngeo emite prolongaciones (futuras criptas) que se introducen en el tejido mesodérmico. En el cuarto mes, este epitelio forma pequeños brotes, constituidos …
Leer MásCILINDROMA ADENOIDE QUÍSTICO SUBMAXILAR
El cilindroma adenoide quístico submaxilar. Tumor de senos nasales accesorios que infiltraba órbita y, que estructuralmente presentaba un estroma hialinomucinoso que a modo de cilindro era envuelto por el componente epitelial. Posteriormente se ha ido sustituyendo por el de carcinoma adenoide-quístico como se conoce en la actualidad. Tienen en general una forma de presentación clínica muy similar a los benignos, …
Leer MásCISTOADENOCARCINOMA MUCINOSO DE OVARIO
El cistoadenocarcinoma mucinoso de ovario. Ver cáncer de ovario.
Leer MásQUISTES SEBÁCEOS
Los quistes sebáceos. Tumor, quiste, etc; normalmente es benigno constituido por una masa circunscrita de tejido adiposo ó constituidos por la proliferación de tejido celular subcutáneo. Es un tumor, quiste, absceso, etc; benigno compuesto de tejido adiposo, a veces encapsulado que se manifiestan como masas redondas bien definidas con una pared visible y homogénea. Tiene un crecimiento lento de masa …
Leer MásSÍNDROME BULBAR ANTERIOR
El síndrome bulbar anterior. Hemiplejía (parálisis de medio cuerpo) de la parte opuesta a la lesión pero cuyos miembros suelen conservar la sensibilidad térmica y dolorosa; suele estar provocada por una lesión de la zona anterior del bulbo que comprende el fascículo piramidal, el lemnisco medio y la raíz del hipogloso. La mitad de la lengua del mismo lado que …
Leer MásTUMOR VESICAL QUE INVADE LA MITAD INTERNA
El tumor vesical que invade la mitad interna (T2a). Tumor maligno en general y especialmente el formado por células epiteliales, a saber. Durante los primeros años de vida de una persona, las células normales se dividen más rápidamente para permitir el crecimiento. El cuerpo está compuesto por billones de células vivas. Las células normales del cuerpo crecen, se dividen formando …
Leer MásTUMOR BORDERLINE MUCINOSO GIGANTE DE OVARIO
El tumor borderline mucinoso gigante de ovario. Ver cáncer de ovario. Si fuese de su deseo le podemos elaborar un plan trofológico personalizado para usted.
Leer MásMELANOMA JUVENIL DE SPITZ
El melanoma juvenil de Spitz. O nevo, nevus de Spitz. Los nevus o melanoma juvenil son tumores o lesiones benignos del sistema melanocítico. Son lesiones cuya importancia viene determinada por su semejanza histológica con los melanomas. El melanoma juvenil o nevó de Spitz es una rara forma de nevó melanocítico benigno que puede ser confundido fácilmente, no sólo con un …
Leer MásLIQUEN RUBER PLANO
El liquen ruber plano. Afección cutánea de origen desconocido a saber que afecta a las muñecas, zonas de flexión de los brazos, muslos, dorso de los pies y las piernas, tronco, y también en la mucosa bucal y genitales, etc. Se caracteriza por la formación de pápulas aplanadas y de color mates que forman un dibujo blanquecino en forma de …
Leer MásTUMOR MALIGNO DE LAS CÉLULAS DE LOS ISLOTES PANCREÁTICOS
El tumo maligno de las células de los islotes pancreáticos. El páncreas es una glándula de aproximadamente seis pulgadas con forma de una pera pequeña que descansa sobre su costado. El extremo más grande del páncreas se llama la cabeza, la sección media se llama el cuerpo y el final angosto se llama la cola. El páncreas descansa detrás del estómago y delante de la columna vertebral. …
Leer MásSÍNDROME DE NEOPLASIA ENDOCRINA MÚLTIPLE (MEN) o (NEM)
También se le conoce con los nombres de (Adenomatosis endocrina múltiple, Adenomatosis endocrina Familiar). Aunque los tumores endocrinos solo representan aproximadamente el 3% de los casos de cáncer recientemente informados, algunas personas desarrollan gran número de estos tumores durante el transcurso de sus vidas debido a condiciones genéticas poco comunes, tales como MEN. Es una enfermedad hereditaria en la cual una o …
Leer MásNEOPLASIA MALIGNA DE LA VÍA BILIAR
La neoplasia maligna de la vía biliar. Es una enfermedad por la cual se forman células malignas cancerosas en los tejidos de la vesícula biliar es una enfermedad poco frecuente por la que se encuentran células cancerosas en los tejidos de la vesícula biliar. Tumor maligno en general y especialmente el formado por células epiteliales, a saber. Los canceres se …
Leer MásNEOPLASIA INTRAEPITELIAL CERVICAL
La neoplasia intraepitelial cervical (NIC, CIN). Los virus del papiloma humano (VPH) de los tipos 16 y 18 son los principales tipos que se asocian al cáncer ginecológico y genital. A saber, sin olvidar a los demás. Tumor maligno casi siempre y especialmente el formado por células epiteliales. Los canceres en grupos o categorías como el carcinoma, sarcoma, adenosarcoma, neoplasias, …
Leer MásNEOPLASIAS MALIGNAS DE LAS AMIGDALAS
Las neoplasias malignas de las amígdalas. Tumor, linfomas, neoplasia-s o muy similar pueden ser atrófico (el escirroso rodeado de tejido escleroso y atrófico), dermoide (el que contiene tapones de epitelio con masas coloideas), escirroso (el duro, fibroide y muy maligno, a saber), etc. Maligno en general y especialmente los formados por células epiteliares.los cánceres se dividen en 2-4 grandes categorías …
Leer MásNEOPLASIA MALIGNA DEL TRACTO URINARIO
La neoplasia maligna del tracto urinario. Tumor maligno en general y especialmente el formado por células epiteliales, se presenta en el parénquima del riñón, es la forma más usual de cáncer y se origina en la proliferación de células epiteliales de los túbulos renales. Es más común en hombres que en las mujeres y no es común que afecte a …
Leer MásNEOPLASIAS MALIGNAS DEL APARATO GENITAL
Las neoplasias malignas del aparato genital. Los virus del papiloma humano (VPH) de los tipos 16 y 18 son los principales tipos que se asocian al cáncer ginecológico y genital. A saber, sin olvidar a los demás. Tumor maligno casi siempre y especialmente el formado por células epiteliales. Los canceres en grupos o categorías como el carcinoma, sarcoma, adenosarcoma, neoplasias, …
Leer Más Binipatia e higienismo Medicina natural alternativa, plantas medicinales y remedios caseros naturales
Binipatia e higienismo Medicina natural alternativa, plantas medicinales y remedios caseros naturales